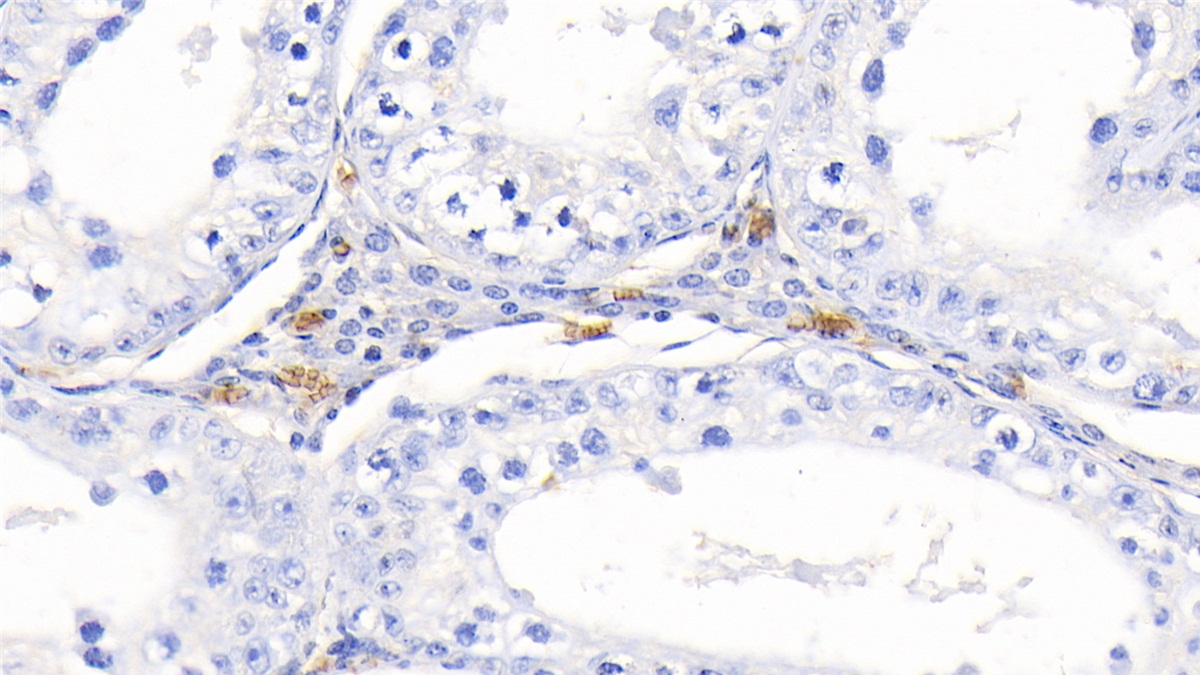

Polyclonal Antibody to Hemoglobin (HB) 

Hgb; Haemoglobin; Heterotetramer(αβ)2
Overview
Properties
- Product No.PAB409Bo02
- Organism SpeciesBos taurus; Bovine (Cattle) Same name, Different species.
- ApplicationsWB; IHC
If the antibody is used in flow cytometry, please check FCM antibodies.
Research use only - DownloadInstruction Manual
- CategoryMetabolic pathwayInfection immunityHematologyNeuro science
- SourcePolyclonal antibody preparation, Host Rabbit
- Ig Type IgG, Potency n/a
- PurificationAntigen-specific affinity chromatography followed by Protein A affinity chromatography
- LabelNone
- Immunogen NPB409Bo01-Native Hemoglobin (HB)
- Buffer Formulation0.01M PBS, pH7.4, containing 0.05% Proclin-300, 50% glycerol.
- TraitsLiquid, Concentration 0.5mg/mL
Sign into your account
Share a new citation as an author
Upload your experimental result
Review

Contact us
Please fill in the blank.
Specifity
The antibody is a rabbit polyclonal antibody raised against HB. It has been selected for its ability to recognize HB in immunohistochemical staining and western blotting.
Usage
Western blotting: 0.01-2µg/mL;
Immunohistochemistry: 5-20µg/mL;
Optimal working dilutions must be determined by end user.
Storage
Store at 4°C for frequent use. Stored at -20°C in a manual defrost freezer for two year without detectable loss of activity. Avoid repeated freeze-thaw cycles.
Stability
The thermal stability is described by the loss rate. The loss rate was determined by accelerated thermal degradation test, that is, incubate the protein at 37°C for 48h, and no obvious degradation and precipitation were observed. The loss rate is less than 5% within the expiration date under appropriate storage condition.
Organism Species More: Homo sapiens (Human)Giveaways
Increment services
Citations
- Effects of ectoine on behavioural, physiological and biochemical parameters of Daphnia magnaPubmed:25460046
- Comparative Proteomics Identifies Host Immune System Proteins Affected by Infection with Mycobacterium bovisPubmed:27027307
- The intracellular bacterium Anaplasma phagocytophilum selectively manipulates the levels of vertebrate host proteins in the tick vector Ixodes scapularis.pubmed:27561965
- Elevated levels of protein AMBP in cerebrospinal fluid of women with preeclampsia compared to normotensive pregnant women.pubmed:27615121
- Chicory inulin ameliorates type 2 diabetes mellitus and suppresses JNK and MAPK pathways in vivo and in vitropubmed:28105758
- Oxidized Hemoglobin Is Antigenic and Immunogenic in Lupuspubmed:28694810
- 新規人工酸素運搬体HemoAct を用いた脳虚血再灌流障害治療開発に関する研究:
- Mural cell-derived laminin-α5 plays a detrimental role in ischemic strokePubmed: 30777135
- Decylubiquinone suppresses breast cancer growth and metastasis by inhibiting angiogenesis via the ROS/p53/BAI1 signaling pathwayPubmed: 32020421
- Water-extractable zinc protoporphyrin IX in Parma ham predominantly exists as complexes with hemoglobin and myoglobin
- Effects of Human Serum Albumin on the Fluorescence Intensity and Tumor Imaging Properties of IR‐780 Dye34687567